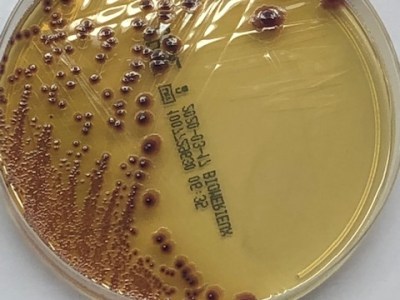
Bacteriuria asintomática

Benvinguts al blog del PROA Bages, Berguedà, Moianès i Solsonès
Clostridium difficile
Clostridium difficile (CD) es un bacilo grampositivo esporulado, que forma parte de la flora intestinal habitual (pacientes portadores) en el 1-3% de la población general y que asciende hasta el 20% en la población institucionalizada. El contagio hospitalario se da a consecuencia de la ingesta de esporas de CD toxigénico (transmisión fecal-oral) que pueden permanecer…
Clostridium difficile
El Clostridium difficile (CD) es tracta d’un bacil grampositiu anaerobi esporulat que forma part de la flora intestinal habitual (pacients portadors) del 1-3% de la població general i que ascendeix fins el 20% en la població institucionalitzada. El contagi hospitalari té lloc a conseqüència de la ingesta d’espores de CD toxigènic (transmissió fecal-oral) que poden…
Bacteriuria asintomática
Se define como bacteriuria asintomática el aislamiento bacteriano en un urinocultivo, recogido de forma correcta, sin que exista sintomatología urinaria acompañante. En muchas ocasiones la bacteriuria asintomática se asocia a piúria, que tampoco es definitoria de infección urinaria. Desde el punto de vista epidemiológico, la bacteriuria asintomática incrementa su prevalencia de forma directamente proporcional a…
Bacteriúria asimptomàtica
Es defineix com a bacteriúria asimptomàtica l’aïllament bacterià en un urinocultiu, recollit de forma correcte, sense que existeixi simptomatologia urinària acompanyant. En moltes ocasions la bacteriúria asimptomàtica s’associa a piúria que tampoc es definitòria d’infecció urinària. Des del punt de vista epidemiològic la bacteriúria asimptomàtica incrementa la seva prevalença de forma directament proporcional a l’edat,…
Mapa de resistències de la zona (2018)
Mostres respiratòries Coprocultius Urinocultius S. aureus Indicadors
La resistencia a los antibióticos
Los antibióticos eliminan las bacterias responsables de las infecciones. Actualmente hay antibióticos para combatir casi todos los tipos de bacterias, pero su uso generalizado y en ocasiones incorrecto, ha hecho que cada vez haya más bacterias resistentes. ¿Que es la resistencia antibiótica? La resistencia a los antibióticos es la capacidad que tienen las bacterias para…
La resistència als antibiòtics
Els antibiòtics eliminen els bacteris responsables de les infeccions. Actualment hi ha antibiòtics per combatre gairebé tots els tipus de bacteris, però el seu ús generalitzat i de vegades incorrecte, ha fet que cada vegada hi hagi més bacteris resistents. Que és la resistència antibiòtica? La resistència als antibiòtics és la capacitat que tenen els…
¡Bienvenidos!
¿Qué es PROA Bages, Berguedà, Moianès y Solsonès? Proyecto para el uso adecuado de los antibióticos en el ámbito ambulatorio. Éste incluye un correcto diagnóstico diferencial (virus-bacteria-otros), la correcta selección del antibiótico, dosis y duración, así como un grado de adherencia adecuado y medidas para la prevención de las infecciones. ¿Quién forma parte? Médicas de…
Benvinguts!
Què és PROA Bages, Berguedà, Moianès i Solsonès? Projecte per a l’ús adequat dels antibiòtics en l’àmbit ambulatori. Aquest inclou realitzar un correcte diagnòstic diferencial (virus-bactèria-altres), la correcta selecció de l’antibiòtic, dosis i durada, així com un grau d’adherència adequat i mesures per a la prevenció de les infeccions. Qui en forma part? Metgesses de…

Sigue nuestro blog
Recibe nuevo contenido directamente en tu bandeja de entrada.